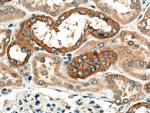
CHMP1B Antibody in Immunohistochemistry (Paraffin) (IHC (P))

Search
Proteintech
CHMP1B Polyclonal Antibody
{{$productOrderCtrl.translations['antibody.pdp.commerceCard.promotion.promotions']}}
{{$productOrderCtrl.translations['antibody.pdp.commerceCard.promotion.viewpromo']}}
{{$productOrderCtrl.translations['antibody.pdp.commerceCard.promotion.promocode']}}: {{promo.promoCode}} {{promo.promoTitle}} {{promo.promoDescription}}. {{$productOrderCtrl.translations['antibody.pdp.commerceCard.promotion.learnmore']}}
产品信息
14639-1-AP
种属反应
已发表种属
宿主/亚型
分类
类型
抗原
偶联物
形式
浓度
规格
纯化类型
保存液
内含物
保存条件
运输条件
产品详细信息
Immunogen sequence: MSNMEKHLF NLKFAAKELS RSAKKCDKEE KAEKAKIKKA IQKGNMEVAR IHAENAIRQK NQAVNFLRMS ARVDAVAARV QTAVTMGKVT KSMAGVVKSM DATLKTMNLE KISALMDKFE HQFETLDVQT QQMEDTMSST TTLTTPQNQV DMLLQEMADE AGLDLNMELP QGQTGSVGTS VASAEQDELS QRLARLRDQV (1-199 aa encoded by BC065933)
靶标信息
CHMP1B belongs to the chromatin-modifying protein/charged multivesicular body protein (CHMP) family. These proteins are components of ESCRT-III (endosomal sorting complex required for transport III), a complex involved in degradation of surface receptor proteins and formation of endocytic multivesicular bodies (MVBs). Some CHMPs have both nuclear and cytoplasmic/vesicular distributions, and one such CHMP, CHMP1A, is required for both MVB formation and regulation of cell cycle progression (Tsang et al., 2006 ).
仅用于科研。不用于诊断过程。未经明确授权不得转售。
生物信息学
蛋白别名: Charged multivesicular body protein 1b; charged multivesicular body protein 1b-1; Charged multivesicular body protein 1B1; CHMP1.5; CHMP1b; CHMP1b-1; chromatin modifying protein 1B; Chromatin-modifying protein 1b; Chromatin-modifying protein 1b-1; similar to CHMP1; unnamed protein product; vacuolar protein sorting 46-2; Vacuolar protein sorting-associated protein 46-2; VPS46 homolog B; Vps46-2
基因别名: 2810405I11Rik; C10orf2; C18-ORF2; C18orf2; CHMP1.5; CHMP1B; Chmp1b1; hVps46-2; Vps46-2; Vps46B
UniProt ID: (Human) Q7LBR1, (Mouse) Q99LU0
Entrez Gene ID: (Human) 57132, (Rat) 689364, (Mouse) 67064